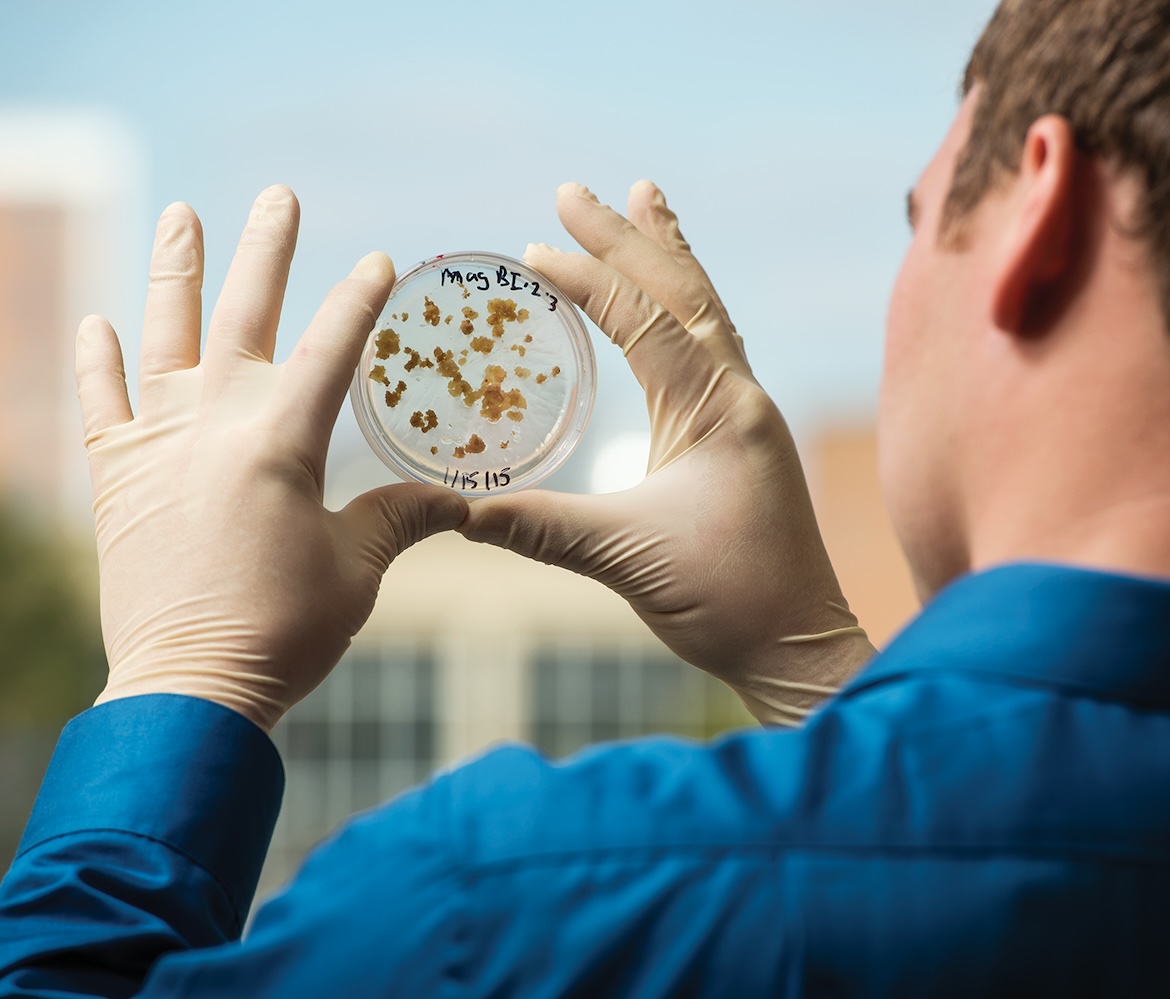

One observer’s list of MTSU majors that deserve more attention—and set graduates up for great careers
MTSU and its so-called marketing experts (like me!) commonly give extensive coverage and marketing love to the “sexier” academic programs on campus. Think Recording Industry, Live Production (Video and Film Production), Concrete and Construction Management, Aerospace, Fermentation Science, and Horse Science.
We do so for good reasons. First off, those programs are stellar and among the best in their class in America. But let’s be honest: From a marketer’s standpoint, they offer a lot of sizzle. Horses? Grammy winners? Distilling? Pilot prep? I mean, c’mon. Can you blame us?
All that said, we know there are numerous degree programs on campus that are (too often) unsung, underestimated, overlooked, underhyped, underheralded, and/or overshadowed (pick your modifier) and deserve some ink.
Many of these are the “nuts and bolts” degree programs that, year after year, go quietly about their business successfully preparing students for fulfilling lives and lucrative careers.
It’s time to shine a spotlight on some of them.
The following, then, is a list of 18 programs at MTSU that don’t always get the marketing love they deserve but are incredibly valuable degrees sure to benefit any graduate (aka, your children, grandchildren, neighbors, and other family members).
They are presented here in alphabetical order, so as to ensure no additional prejudice.
Note: This is just one editor’s educated opinion. Are there degree programs at MTSU that should be on this list that aren’t? Yes! Literally, dozens! This list, then, is simply intended to draw attention to and be reflective of the myriad dynamic and diverse degree programs available at MTSU flying too far under the radar.
Accounting

Don’t sleep on this career path to earn financial success. Our graduates are recruited by more than 100 companies in the metropolitan Nashville area. The Accounting Department offers both the B.B.A. in Accounting and the Master in Accountancy (M.Acc.) degrees. By moving much of the coursework online, the Jones College of Business experienced a whopping 50% increase in enrollment in its Accounting program between fall 2023 and fall 2024. New curriculum options that fill real-world needs are soon to include anti-money laundering coursework. Industries ranging from law enforcement to the financial services industry to online gaming have expressed interest in such curriculum.
Actuarial Science

Another high-earning career based in numbers that is nothing to yawn about. Actuaries are the go-to problem solvers for businesses that need to manage financial risk. And every business manages financial risk. MTSU is the only university in Tennessee that offers actuarial science coursework for both undergraduate and graduate degrees. In 2024, MTSU was recognized as a Society of Actuaries Center of Actuarial Excellence, placing it among the top 40 schools in the world . Combine that with the Gold Level Recognition given by the Casualty Actuarial Society, another major actuarial society. MTSU is among only nine schools in the world with both these recognitions.
Animation

Now, don’t get me wrong. Animation is without question as sexy as programs like Recording Industry and Video and Film Production, which are also housed in the College of Media and Entertainment. It’s just that Animation gets overshadowed by those more established programs that boast such rich histories. MTSU’s Animation program is ranked tops in Tennessee by Animation Career Review (ACR), an online national and international ranking resource for animation schools. ACR also ranks MTSU No. 8 among the Top 25 Animation B.S. Programs in the U.S. (out of 199 schools). Growth in special effects and multimedia animation in film, video games, and other media are driving career prospects.
Biology / Chemistry / Physics / Math
Yes, I cheated and grouped the four curriculum pillars of the College of Basic and Applied Sciences, and I did so because it’s the same argument for all. Each prepares students for problem-solving / critical thinking, analyzing / interpreting data, making observations / drawing conclusions, complicated / advanced mathematics, and counterintuitive thinking—all of which prepare students broadly to succeed in a wide range of fields.

Such skills are crucial to science careers but also translatable to the business world. Mathematicians and physicists commonly go into trading or the financial sector. Physics majors frequently become engineers. All four disciplines also translate well to the medical fields and, increasingly, to law (intellectual property, patent, digital privacy) or any profession valuing technical backgrounds.
Communication

Good communication is the backbone of any successful workplace. The Communication major, grounded in the liberal arts tradition at MTSU, builds valuable assets that can lead to many rewarding career opportunities in today’s dynamic workforce. The ability to communicate effectively is one of the skills most highly sought by employers. The National Association of Colleges and Employers (NACE) Job Outlook 2020 Survey found that the knowledge and skills taught in communication courses are essential to being hired. The Communication major takes a generalist approach, with concentrations available in Culture and Social Influence or in Organizational Communication. Surely we can all agree that what the world needs now is better communication!
Computer Science / Data Science

Combined (again, unartfully) because the same case can be made for each. MTSU’s high-tech graduates commonly land at Amazon, Google, Microsoft, and Meta, to name a few. Data collection has become a kind of currency over the past decade, but most companies don’t specialize in analyzing it to make better business decisions. As a result, data science has emerged as a valuable new strategy in corporate circles.

MTSU’s Data Science Institute, the first of its kind in the Midstate, develops public and private collaborations, and provides invaluable, real-world study opportunities for students. The Computer Science Department, meanwhile, produces graduates capable of designing, implementing, and documenting computer software systems—marketable skills in any economy.
Cybersecurity Management

The newest degree option on the list (it just launched in 2024!), Cybersecurity Management paves the way for graduates to pursue positions such as security analysts and information security managers. The degree covers areas including cloud computing, digital forensics, infrastructure design and management, database design, and systems analysis and design—all from a cybersecurity perspective. Electronic data is foundational to modern commerce and industry, and MTSU is the only university in Tennessee with a degree related explicitly to cybersecurity management.
All MTSU degrees related to teacher preparation at every level

More than 113 years after being founded as a teacher training college, MTSU is still the No. 1 producer of teachers in the greater Nashville area. Educator, counselor, librarian, or education leader are some of the most important jobs in the world because the day-to-day work has the potential to shape the minds and actions of future leaders. Graduates of MTSU’s undergraduate and graduate licensure programs are highly sought after by school districts. Placement rate after graduation is essentially 100%. MTSU also excels in education research, including through its world-renowned Tennessee Center for the Study and Treatment of Dyslexia. MTSU’s College of Education is also the nexus of continuing education for professional educators across Tennessee.
Industrial-Organizational Psychology

I-O Psychology is the psychology of the workplace and employee behaviors. Students learn how to hire and train effectively by applying evidence-based practices to organizational challenges. Career specialties include recruitment and selection of employees, training, job analysis, compensation, performance measurement and talent development, leadership, work attitudes, occupational health, organizational development, and more. According to U.S. News and World Report, industrial-organizational psychologist ranks No. 2 in Best Science Jobs (just behind psychologist). But I’ve buried the lede . . . MTSU is one of only a few universities across the nation to offer a bachelor’s degree in I-O Psychology. Even more spectacular, MTSU’s I-O Psychology master’s program has been ranked the No. 1 such program in the United States by the Society for Industrial and Organizational Psychology!
Journalism

Whether it’s joining MTSU’s student-run newsroom, calling games for ESPN+, or working for the University’s in-house advertising agency, the MTSU School of Journalism and Strategic Media offers something for every student looking for a career in media. The Center for Innovation in Media brings together the University’s two campus radio stations, WMOT and WMTS, and the school news outlet, Sidelines, along with TV broadcasting facilities used by the Middle Tennessee student news team. This collaborative space enhances the student experience with opportunities to acquire and use the digital media skills needed in today’s newsrooms. Highlighting one of six concentrations here, the school offers an Investigative Journalism concentration that speaks loudly to the world we live in today. In it, future members of the Fourth Estate are challenged to examine the status quo and identify stories and groups that mainstream media often underserve.
Marketing—Professional Selling

Like real estate or entrepreneurialism, you don’t normally think of going to college to be an effective salesperson. But like Real Estate and Entrepreneurship, which are MTSU academic programs, MTSU offers a Marketing degree with a concentration in Professional Selling. The benefits of a sales career include high earning potential, the opportunity for travel, career advancement, a daily variety of tasks, and helping people and businesses. Students within the program have access to MTSU’s Center for Professional Selling, as well as the Mel Adams State Farm Agent Professional Sales Lab, which allows them to practice real-world selling scenarios to hone their skills. MTSU is one of only 62 universities from the U.S. and Europe accepted as an associate member of the University Sales Center Alliance, an organization dedicated to preparing students for success in professional sales roles.
Nutrition and Food Science

Nutrition programs significantly impact America by producing qualified dietitians and nutritionists who play a crucial role in promoting public health—by educating individuals on healthy eating habits, managing chronic diseases like diabetes and heart disease through dietary interventions, and advocating for better food policies, ultimately contributing to a healthier population nationwide. With its multivarious majors and concentrations, MTSU’s Nutrition and Food Science program has great potential to impact public health at a time when threats to health—particularly from high obesity rates—are rampant. The Nutrition and Food Science major provides preparation for careers in community nutrition services; county, state, and federal health departments; food systems management; food processing; food marketing; and quality control.
Public Writing and Rhetoric

One of MTSU’s most innovative new majors, Public Writing and Rhetoric is an interdisciplinary undergraduate program and the first major of its kind in Tennessee What separates it from the more established concentrations in English? It is built around a core set of classes meant to introduce students to a wide range of writing strategies, writing contexts, and genres that they might use for personal and public purposes, as well as in professional contexts. Working with faculty who research and teach courses on technical writing, video games, community and public rhetorics, digital reading practices, podcasting, collaborative writing, and user experience design, students in the program become dynamic, rhetorically adaptable writers prepared to navigate a wide range of audiences, genres, and platforms (think content strategist, grant writer, social media manager, or user experience designer, to name a few). In a world where employers put a premium on flexible, well-developed writing skills, Public Writing and Rhetoric majors and minors graduate with both in-demand professional skills and the ability to make a difference with their writing.
Integrated Studies

Check out MTSU’s degree completion program! Students who have accumulated a variety of course credits that are not easily applied to a particular degree program often find that they can be used to earn a Bachelor of Science in Integrated Studies, allowing them to graduate sooner. Instruction to complete the degree is offered on the MTSU campus as well as online. This degree is extremely flexible and is an excellent option for students seeking a broad-based educational experience or wanting to custom-design a degree program. This program is also a favorite among adult learners with college-level learning derived from work experience. Elective course requirements for adult learners are often fulfilled through the Prior Learning Assessment program, which evaluates college-level learning gained through work, training, certifications, licensure, military, and other programs.

COMMENTS ARE OFF THIS POST